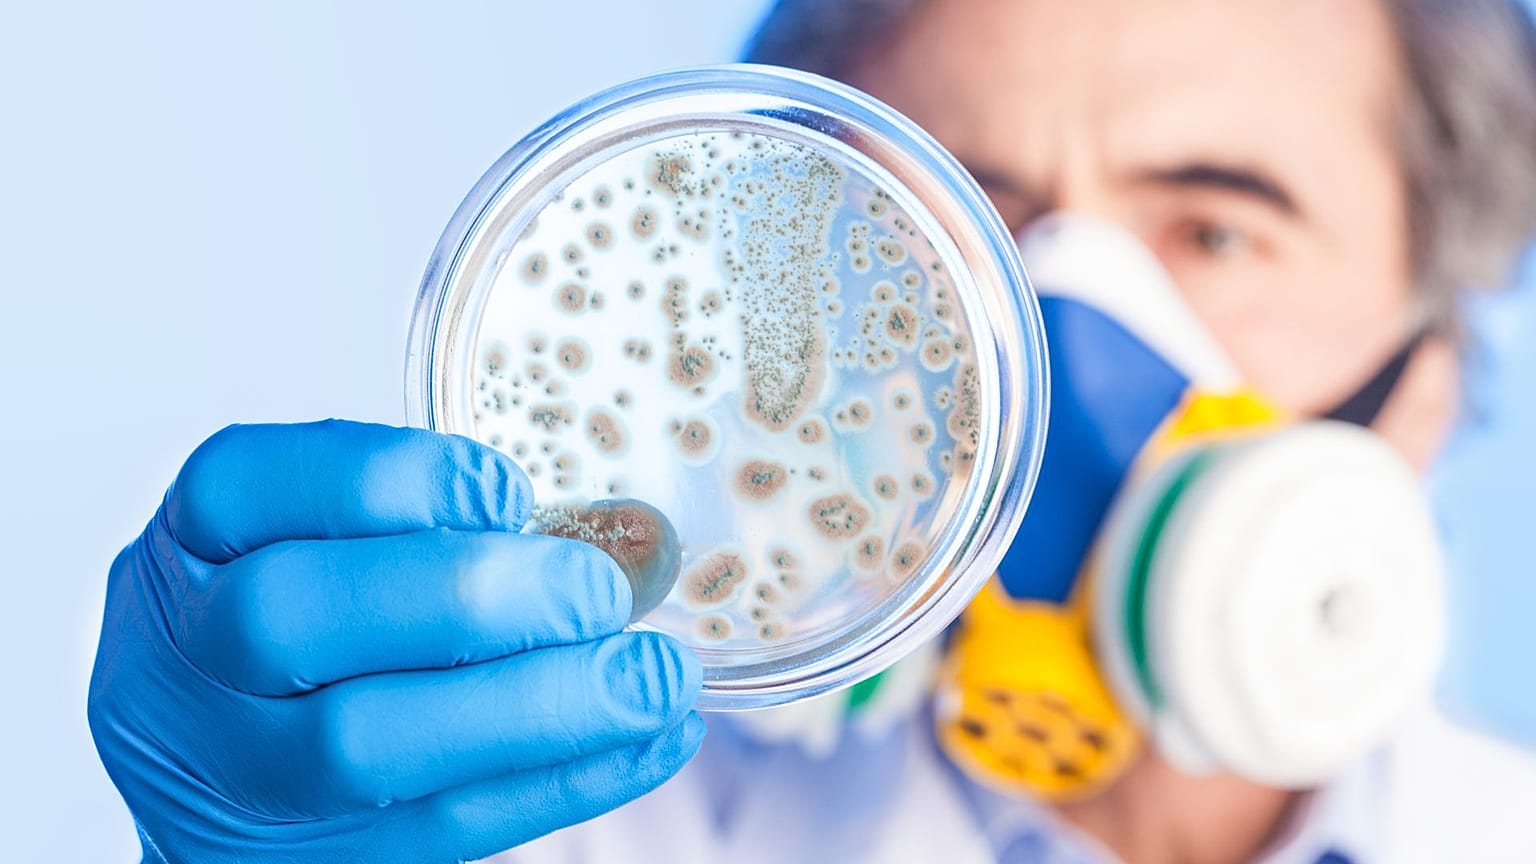
Bacteria

Helsinki-based startup Resistomap has raised €2 million to develop a biosecurity intelligence platform - a new tool to monitor antibiotic resistance.
The days when catching a cold could mean a death threat are over - or so we thought.
 ADVERTISEMENT
ADVERTISEMENT
 ADVERTISEMENT
ADVERTISEMENT
The World Health Organization (WHO) has kicked off its annual World AMR Awareness Week, starting on 18 November, with a focus on the theme of "Preventing antimicrobial resistance together".
Around the world, antimicrobial-resistant bacteria take the lives of millions every year - around 35,000 of which are in the EU - with huge cost to the global economy.
Helsinki-based startup Resistomap has joined the fight against antimicrobial resistance and has secured €2 million from investors to take it to the next level by building a biosecurity intelligence platform to find known and undiscovered pathogens.
"Our vision goes beyond AMR [antimicrobial resistance] to build a comprehensive biosecurity platform that addresses a diverse array of disease-causing pathogens, encompassing both those already identified and those that remain undiscovered,” said Resistomap CEO Windi Muziasari in a press release.
Mitigating the global threat of antimicrobial resistance
AMR occurs when microbes mutate or adapt in ways that enable them to withstand drugs with antimicrobials.
The race is between scientists - developing new and stronger antibiotics - and bacteria, which have become resistant due to the extensive use of antibiotics.
AMR is often referred to as the 'silent pandemic', and it has contributed to an estimated 5 million fatalities in 2019, a number predicted to soar to 10 million by 2050.
Over the past four years, Resistomap has been working on mapping antibiotic resistance across the globe, gradually building up a collection of over 10,000 environmental samples from 45 countries, using that to monitor the trends of potential outbreaks, among others.
The fresh funding is going to finance their efforts to turn all this into an intelligence platform that will include "early-warning systems, in-depth genetic results, advanced prediction models on the spread of AMR and personalised recommendations for reducing its dissemination", according to the company.
The funding round was led by European venture capital firm Ananda Impact Ventures with participation from US-based co-investor Gaingels and further support from Business Finland's R&D grant.
“Curbing the spread of antibiotic resistance is critical and there is a great need for innovative solutions to accomplish this,” said Tuomas Harju, senior adviser at Business Finland.
A high-yield investment for any country
Drug-resistant infections pose a huge threat to the economy, the World Bank states in various reports, comparing the potential damage to that of the 2008–2009 global financial crisis's most severe consequences.
Their calculations showed that if nothing was done, AMR could wipe out 3.8% of the world's annual GDP by 2050, with an annual shortfall of $3.4 trillion (€3.1 trillion) by 2030.
This would be enough to push 28 million more people into extreme poverty, inflate global healthcare costs by up to $1 trillion a year, and hit international trade and livestock production the hardest, reducing the latter annually by up to 7.5% globally.
The World Bank estimated that annual investments of $9 billion in low- and middle-income countries are needed to address AMR, but added that putting resources into stopping it is one of the highest-yield investments countries can make.